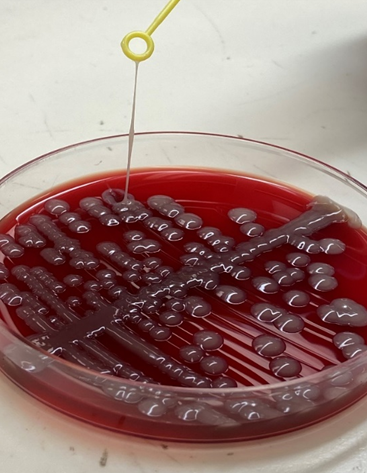
MMPG Chart

Pathology
Molecular Microbiology and Pathogen Genomics (MMPG) Laboratory
Molecular Microbiology and Pathogen Genomics (MMPG) Laboratory
Director: Shaun Yang, PhD, D(ABMM), MLS(ASCP)
Associate Clinical Professor, Department of Pathology and Laboratory Medicine
Associate Medical Director, Clinical Microbiology Laboratory

Scope
The UCLA MMPG Laboratory, within the section of clinical microbiology, provides cutting-edge molecular diagnostics for pathogen detection, quantification, and anti-microbial resistance (AMR) prediction by integrating the most advanced next-generation sequencing (NGS) technologies with pathogen-focused bioinformatics for microbial whole-genome sequencing (WGS) and metagenomics testing, solving the unmet clinical needs in diagnosing and treating challenging infectious diseases.
The MMPG Laboratory also performs real-time institution-level microbial genomic surveillance for outbreak investigation, emerging pathogen characterization, and AMR monitoring, providing timely and highly actionable information to guide infection prevention and treatment optimization.
Mission
- Solving unmet clinical needs and combating emerging pathogens and anti-microbial resistance (AMR) by integrating the most advanced molecular diagnostics and genomics technologies in microbiology.
- Serving the UCLA patients with the state-of-the-art diagnostics for challenging infectious diseases.
- Serving the community with a robust and highly sensitive real-time genomic surveillance program for early detection of novel pathogens and AMR mechanisms locally.
MMPG Workflow


Patient Impact
Patient Impact: Story 1
•Clinical, microbiological, and genomic characteristics of clade-III Candida auris colonization and infection in southern California, 2019-2022
•Multi-drug resistant Candida auris is an emerging fungal pathogen threatening patients’ safety. The UCLA MMPG lab conducted a genomic surveillance of C. auris in the LA metro area. This study highlights our multidisciplinary efforts in fighting this emerging drug-resistant fungal pathogen. This work is in collaboration with our hospital infection prevention team to prevent the spread of this deadly fungus and thus make our hospital environment safer for patients.

Patient Impact: Story 2
•Disguised as Ovarian Tumor: A Rare Case of Uterine Abscess due to Hypervirulent Klebsiella pneumoniae Infection
•A seemingly ovarian tumor turned out to be an infection (uterine abscess) caused by an emerging pathogen named hypervirulent Klebsiella pneumonia (hvKp), discovered by the clinical genotyping capability of the UCLA MMPG lab, which helped preserve the patient’s right ovary, and contributed to a successful treatment. This case highlights the importance of a multidisciplinary effort for the effective diagnosis and management of hvKp infections, which is on the rise in the SoCal community.

Patient Impact: Story 3
•Reinfection or relapse? A case study of whole genome sequencing guided genomic characterization of Mycobacterium abscessus chronic infection in a cystic fibrosis patient
Recurrent Mycobacterium abscessus infections are great challenges in cystic fibrosis patients. The UCLA MMPG Lab utilized whole-genome sequencing (WGS) that enabled high-resolution phylogenetic comparison of M. abscessus differentiating re-infection from relapse in a kid with cystic fibrosis, and demonstrated that differentiating re-infection from relapse can be useful in managing recurrences of M. abscessus infections.

Community Impact
Community Impact: Story 1
•Extensively Drug-Resistant Shigella Discovered in Southern California, 2022
•The UCLA MMPG lab discovered an extensively drug-resistant (XDR) Shigella in an immunocompetent man who has sex with men with persistent, refractory shigellosis. Whole-genome sequencing augmented phenotypic antimicrobial susceptibility testing to comprehensively profile bacterial drug resistance and appropriately guide therapy and clear the infection. The early detection of XDR Shigella in the community sends an alarm for a potential outbreak and warrants public health intervention and clinicians’ awareness.

Community Impact: Story 2
•Clinical Whole-Genome Sequencing Assay for Rapid Mycobacterium tuberculosis Complex First-Line Drug Susceptibility Testing and Phylogenetic Relatedness Analysis
•The global rise of drug resistant tuberculosis has highlighted the need for improved diagnostic technologies that provide rapid and reliable drug resistance results. The UCLA MMPG Lab developed a whole genome sequencing (WGS)-based test for identification of mycobacterium tuberculosis complex (MTB) drug resistance, which provides results more than one month faster than conventional methods. WGS-based testing for MTB drug resistance has the potential to greatly improve diagnosis of drug resistant MTB by accelerating turnaround time while maintaining accuracy and providing additional benefits for infection control, lab safety, and public health applications.

Community Impact: Story 3
•Domestically Acquired NDM-1-Producing Pseudomonas aeruginosa, Southern California, USA, 2023
The UCLA MMPG Lab discovered a case of New Delhi metallo-β-lactamase (NDM) 1–producing carbapenem-resistant Pseudomonas aeruginosa (CRPA) with extensive drug resistance (XDR). Whole-genome sequencing revealed the isolate was genetically distinctive, despite ≈95% similarity to other global strains. The patient’s lack of international travel suggests this CRPA was acquired domestically. The discovery of a local spread of NDM-1 producing CRPA sounded the alarm for the SoCal medical community to embrace for another XDR pathogen that’s challenging to treat.

Research & Innovation
Research & Innovation: Story 1
•Fungal Whole-Genome Sequencing for Species Identification: From Test Development to Clinical Utilization
•The UCLA MMPG Lab developed and validated a whole-genome sequencing (WGS)-based clinical test for fungal species identification on clinical isolates. This test particularly benefits transplant and cancer patients, who are at a high risk for fungal infections. We demonstrated the accurate fungal species identification by WGS led to correct diagnosis and treatment adjustment. This study provides a model for validation and implementation of WGS for fungal identification in a complex health system that serves a large immunocompromised patient population.

Research & Innovation: Story 2
•Validation, Implementation, and Clinical Utility of Whole Genome Sequence-Based Bacterial Identification in the Clinical Microbiology Laboratory
•The application of next-generation sequencing extends from microbial identification to epidemiologic insight and antimicrobial resistance prediction. The UCLA MMPG Lab developed and implemented whole-genome sequencing (WGS) for pan-bacterial identification and showed positive impact on patient care.

Research & Innovation: Story 3
•Metagenomic Sequencing of Positive Blood Culture Fluid for Accurate Bacterial and Fungal Species Identification
•With blood stream infections (BSIs) representing a major cause of mortality and morbidity worldwide, blood cultures play a crucial role in diagnosis, but their clinical application is dampened by the long turn-around time and the detection of only culturable pathogens. The UCLA MMPG Lab developed and validated a shotgun metagenomics next-generation sequencing (mNGS) test directly from positive blood culture fluid, allowing for the identification of fastidious or slow growing microorganisms more rapidly, especially for anaerobes and mycobacteria.

Research & Innovation: Story 4
•Clinical Whole Genome Sequencing for Clarithromycin and Amikacin Resistance Prediction and Subspecies Identification of Mycobacterium abscessus
•Mycobacterium abscessus infections are an emerging health care concern in patients with chronic pulmonary diseases, leading to high morbidity and mortality. One major challenge is resistance to clarithromycin, a cornerstone antibiotic with high efficacy. Therefore, treatment is primarily guided by phenotypic susceptibility results of clarithromycin, which requires extended incubation to assess for inducible resistance. The UCLA MMPG Lab developed a clinical whole genome sequencing (WGS) assay for clarithromycin and amikacin resistance with 100% accuracy and faster turn-around-time. WGS can also provide subspecies identification and high-definition phylogenetic information for more accurate M. abscessus strain typing.

Research & Innovation: Story 5
•Amplicon-Based Next-Generation Sequencing for Detection of Fungi in Formalin-Fixed, Paraffin-Embedded Tissues: Correlation with Histopathology and Clinical Applications
•Invasive fungal infections are increasing in prevalence because of an expanding population of immunocompromised individuals. To reduce morbidity and mortality, it is critical to accurately identify fungal pathogens to guide treatment. Current methods rely on histopathology, fungal culture, and serology, which are often insufficient for diagnosis. The UCLA MMPG Lab developed a next-generation sequencing (NGS) assay for the identification of fungal etiology in fungal stain–positive formalin-fixed, paraffin-embedded (FFPE) tissues with 100% accuracy, which can improve both the speed and the accuracy of diagnosis for invasive fungal infections.

Pathogen Discoveries
Pathogen Discoveries: Story 1
•Endofungal Mycetohabitans rhizoxinica Bacteremia Associated with Rhizopus microsporus Respiratory Tract Infection
•A mysterious bacteria was isolated from a cancer patient’s blood, which couldn’t be identified by conventional tests. Whole-genome sequencing solved the puzzle and unrevealed the bacteria as a symbiont living inside a deadly mold and serving as a warning for invasive mucomycosis. This was the first confirmed case showing the link between endofungal bacteria and invasive mucomycosis discovered by the UCLA MMPG Lab.

Pathogen Discoveries: Story 2
•Clinical and genomic characterization of hypervirulent Klebsiella pneumoniae (hvKp) infections via passive surveillance in Southern California, 2020-2022
•Hypervirulent Klebsiella pneumoniae (hvKp) is more invasive and virulent than classical K. pneumoniae, and requires specialized treatment. The UCLA MMPG Lab developed an accurate NGS test for the identification of hvKp, and performed a genomic surveillance of hvKp in Southern California. We found that hvKp infections were more common than expected, accounting for 2.6% of invasive K. pneumoniae infections, and presented with a wide disease spectrum, occasionally mimicking tumors. Most infections were community acquired with no recent international travel, suggesting hvKp strains are circulating in the community. Our findings highlight the urgency of heightened awareness of hvKp infection in the US and the need for rapid diagnosis of hvKp.
Pathogen Discoveries: Story 3
•Catheter-Related Bloodstream Infection Caused by Mycolicibacterium iranicum
•Mycolicibacterium iranicum is an emerging cause of respiratory, wound, blood, and central nervous system infections. The UCLA MMPG Lab utilized next-generation sequencing (NGS) to identify a case of catheter-related bacteremia caused by Mycolicibacterium iranicum. The case highlights the value of using NGS to identify infrequent and emerging pathogens.

Education & Training
UCLA Molecular Microbiology and Pathogen Genomics (MMPG) NGS Workshop Curriculum
Program Director: Shaun Yang, PhD, D(ABMM), MLS(ASCP)
Open for all UCLA Medical Students, Clinical Trainees, and Faculty Members
(Fall annually, 4 month, starts the 3rd week of July, ends the 2nd week of November)
Weekly Schedule
- Monday: 2pm - NGS Lecture (Hybrid: SY Office & Zoom)
- Tuesday: 2pm - NGS Technical Meeting (Hybrid: Conference Room & Zoom)
- Wednesday: 2pm - NGS Computer Lab (Hybrid: SY Office & Zoom)
- Thursday: 2pm - mNGS Board Meeting (Hybrid: SY Office & Zoom)
Wet-lab Training
- Observation: shadow CLS on Thursday and Friday during routine clinical NGS run
- Hands-on: specific NGS project training by 2nd-year micro fellows
Lectures (Monday at 2pm)
- Introduction to NGS Technologies (by Dr. Shaun Yang)
- Introduction to Microbial Genomics (by Dr. Shaun Yang)
- Introduction to Microbial Bioinformatics (by Dr. Shaun Yang)
- Introduction to Clinical Applications of NGS in Infectious Diseases (by Dr. Shaun Yang)
- Using NGS for Outbreak Investigation (by Dr. Shaun Yang)
- Shotgun Metagenomics for Pathogen Detection (by Dr. Shaun Yang)
- Genomic Prediction for Antimicrobial Resistance in Bacteria (by Dr. Shaun Yang)
- Genomic Prediction for Antimicrobial Resistance in Fungus (by Dr. Shaun Yang)
- Real-world Implementation of NGS in Infectious Diseases Diagnosis and Management (by Dr. Shaun Yang)
- Species Identification of Bacteria (Invited Speaker)
- Species Identification of Fungi (Invited Speaker)
- Genomic Surveillance for Viral Pathogens (Invited Speaker)
- Viral Sequencing by NGS for Antiviral Resistance (Invited Speaker)
- Genotyping of Hyper-virulent K. pneumoniae (Invited Speaker)
- AMR Prediction for MTB (Invited Speaker)
- AMR Prediction for NTM (Invited Speaker)
NGS Technical Meeting: (Tuesday at 2pm)
- Discussion of technical and operational issues
- Determination of samples to be included for the weekly NGS run
- Assignment of data analysis and case review
- Quality management issues
- Quality improvement projects
- Test development and validation
Computer Lab: (Wednesday at 2pm)
- Live demo/training by advanced bioinformatics software users
- Industry demo/training by bioinformatics software vendors
NGS Board Meeting: (Thursday at 2pm)
- Case review and interpretation of any results related to NGS, such as metagenomics or WGS
- Case review and analysis of WGS data regarding AMR prediction and understanding of AMR molecular mechanisms
- Case review and analysis of WGS data for epidemiological investigation studies
- Update of microbial NGS test development/validation projects
- Update of microbial NGS research projects